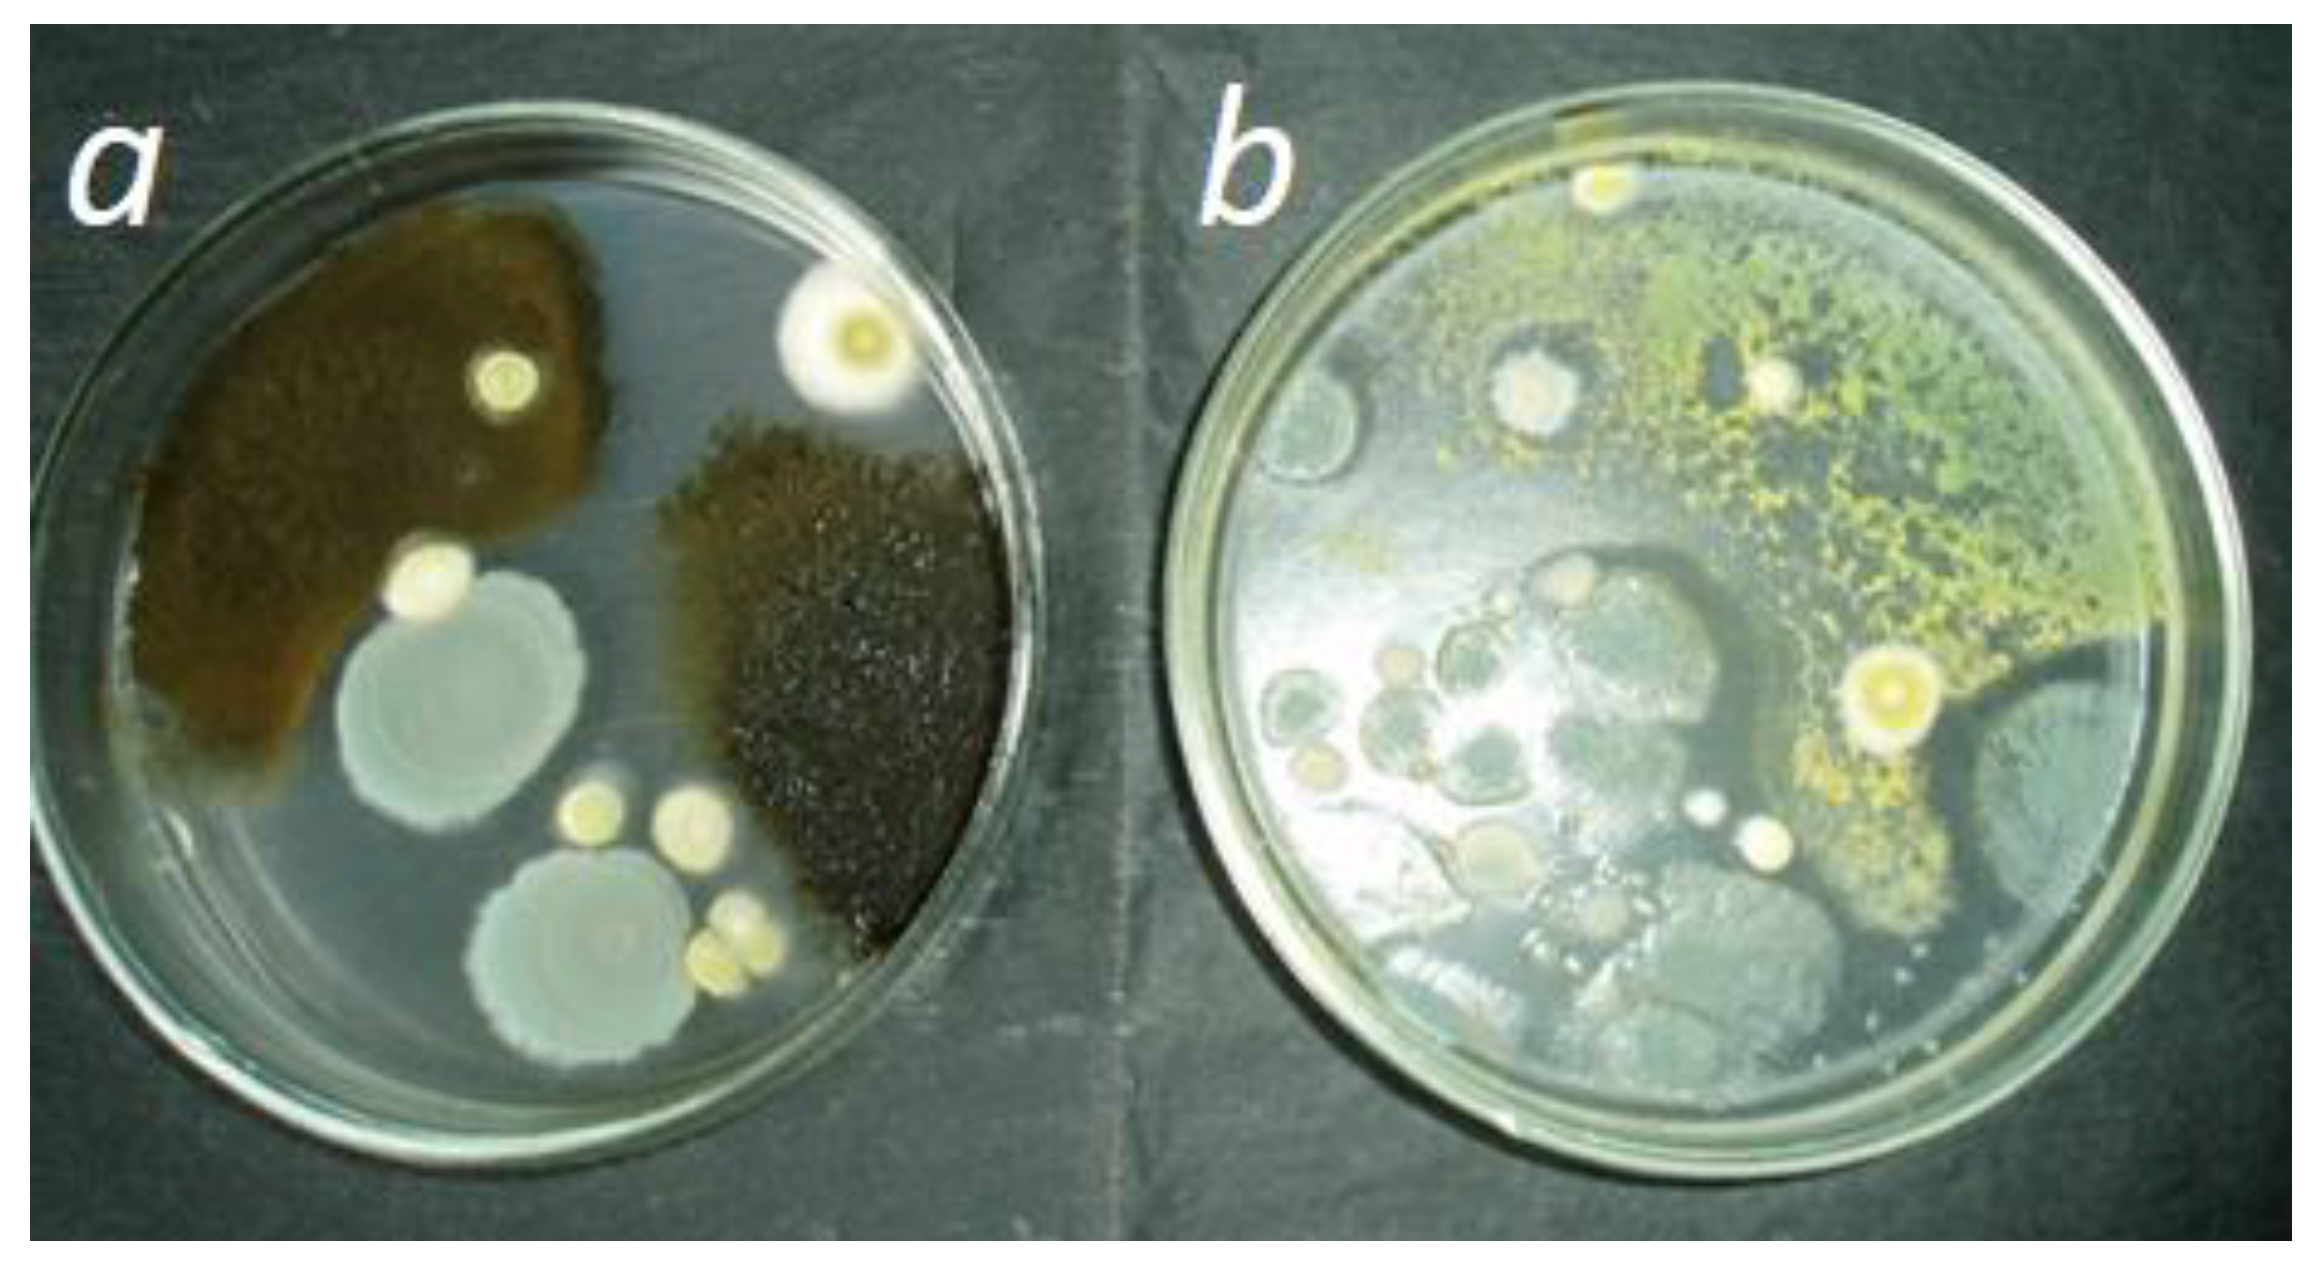
Agronomy 14 01498 g003 Agronomy 14 01498 g003
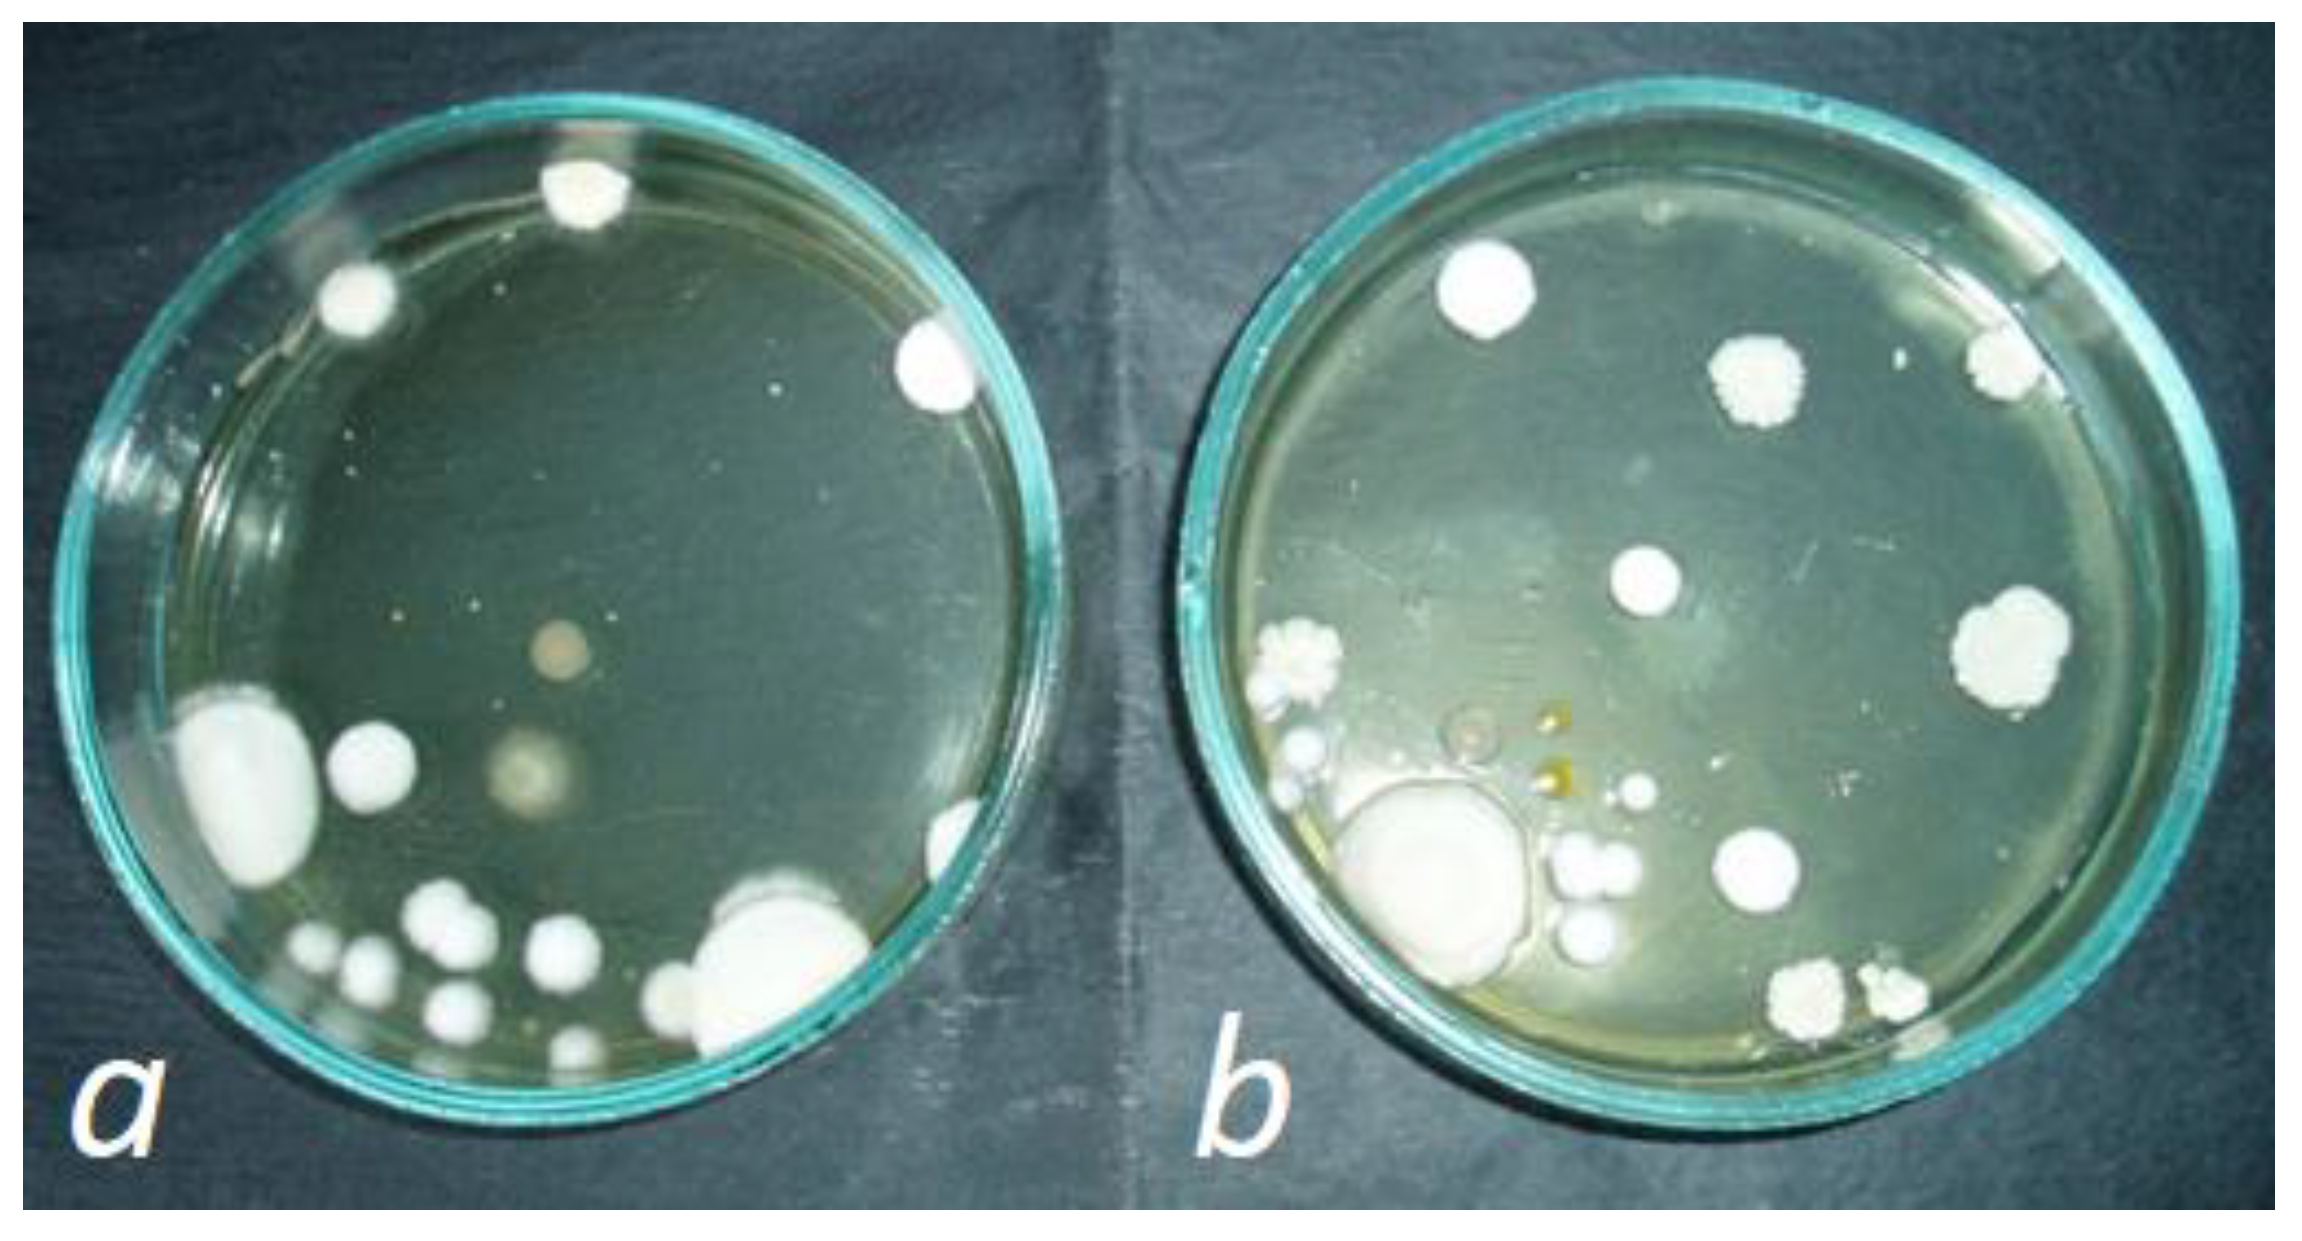
Agronomy 14 01498 g004 Agronomy 14 01498 g004
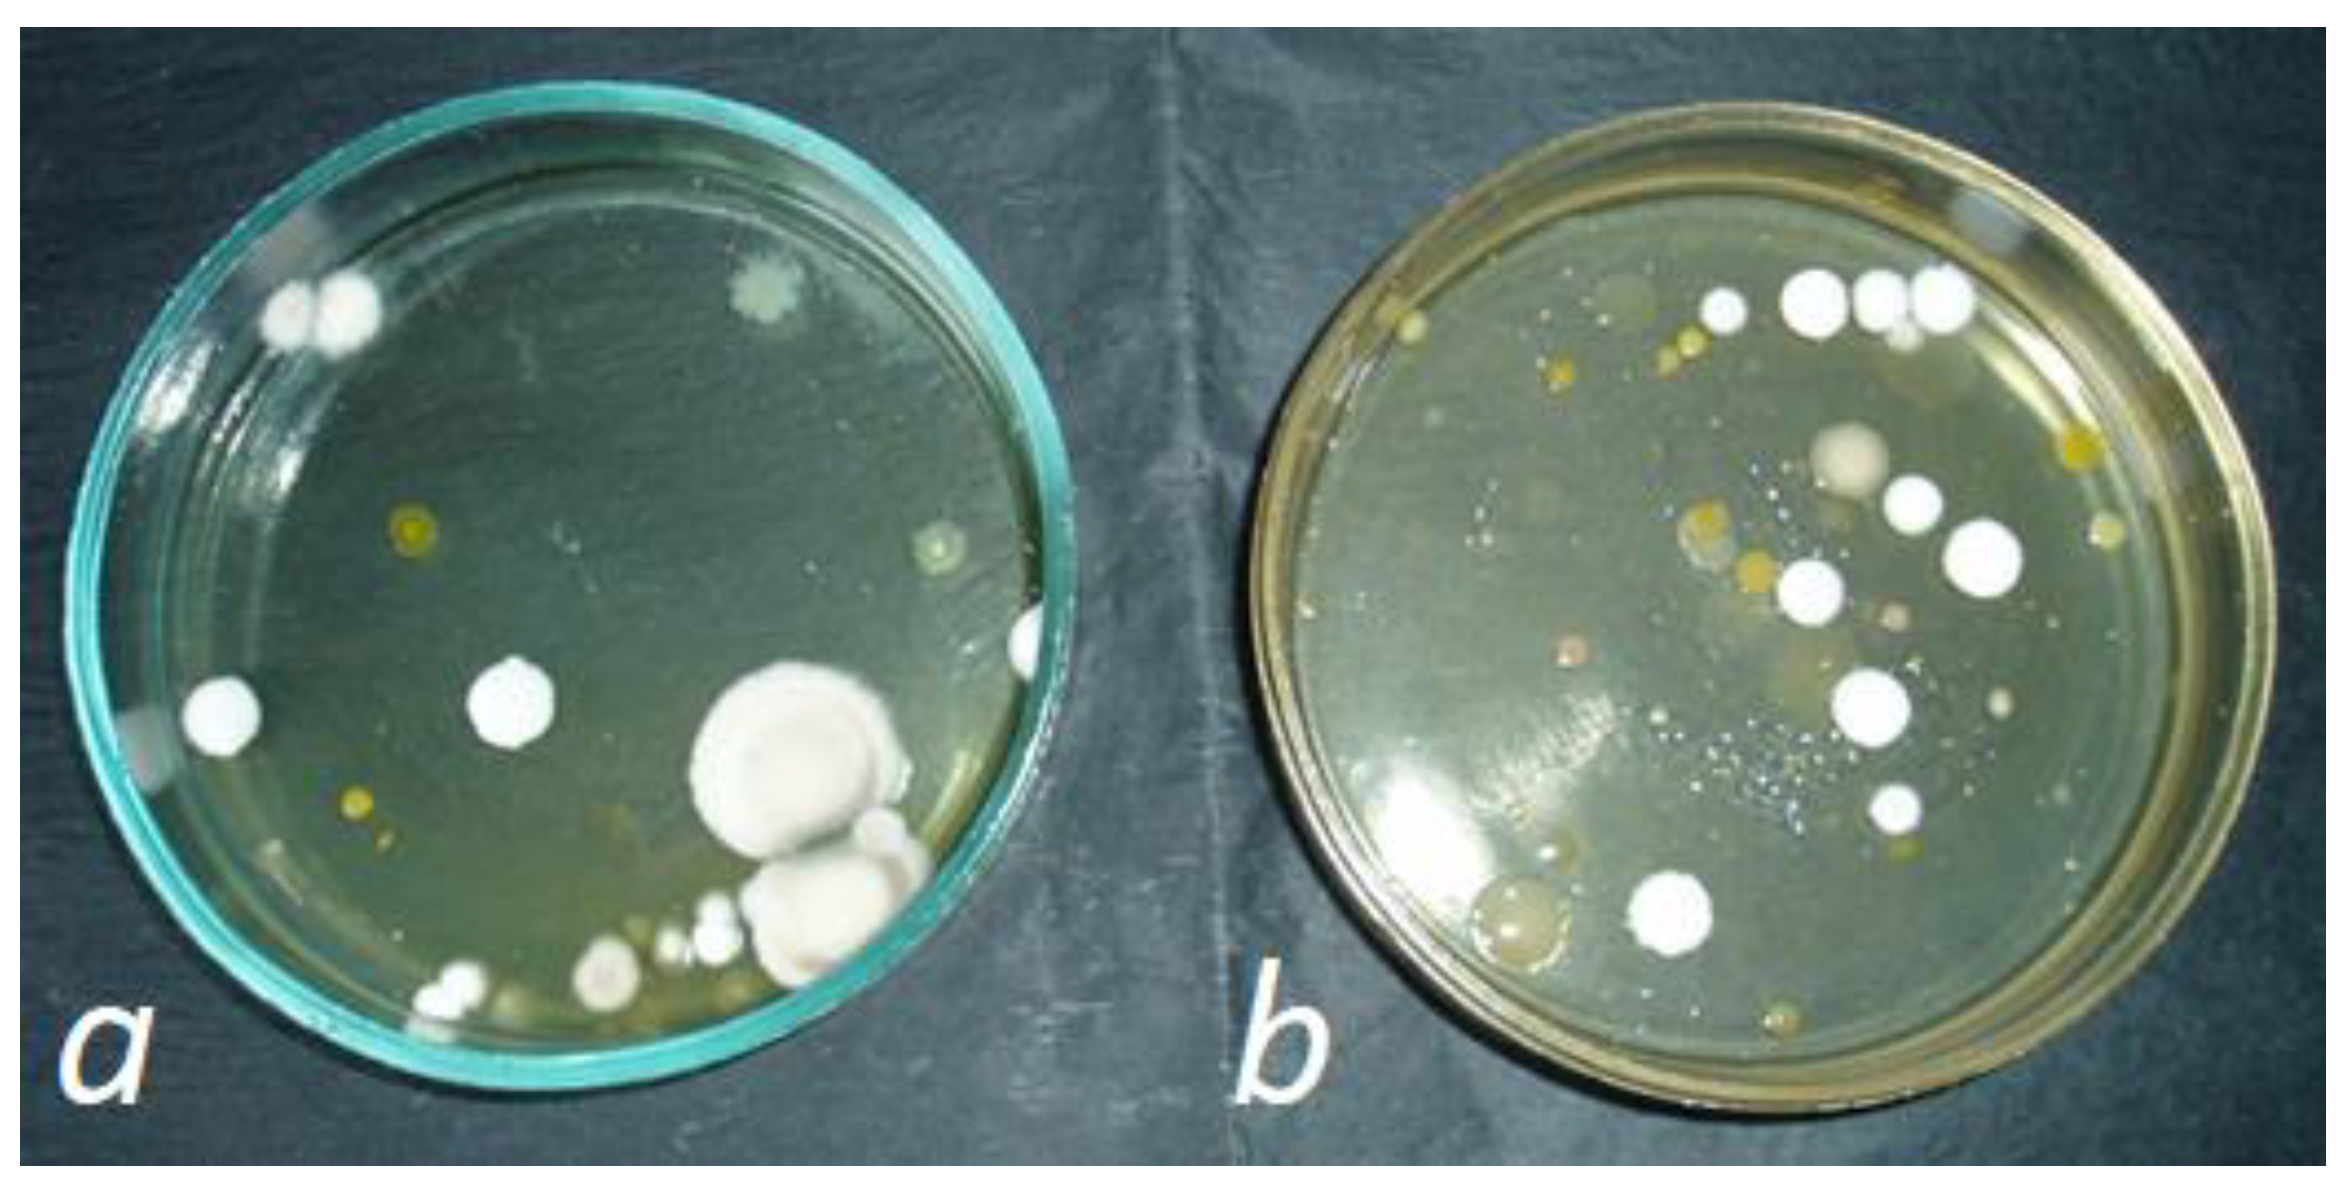
Agronomy 14 01498 g005 Agronomy 14 01498 g005
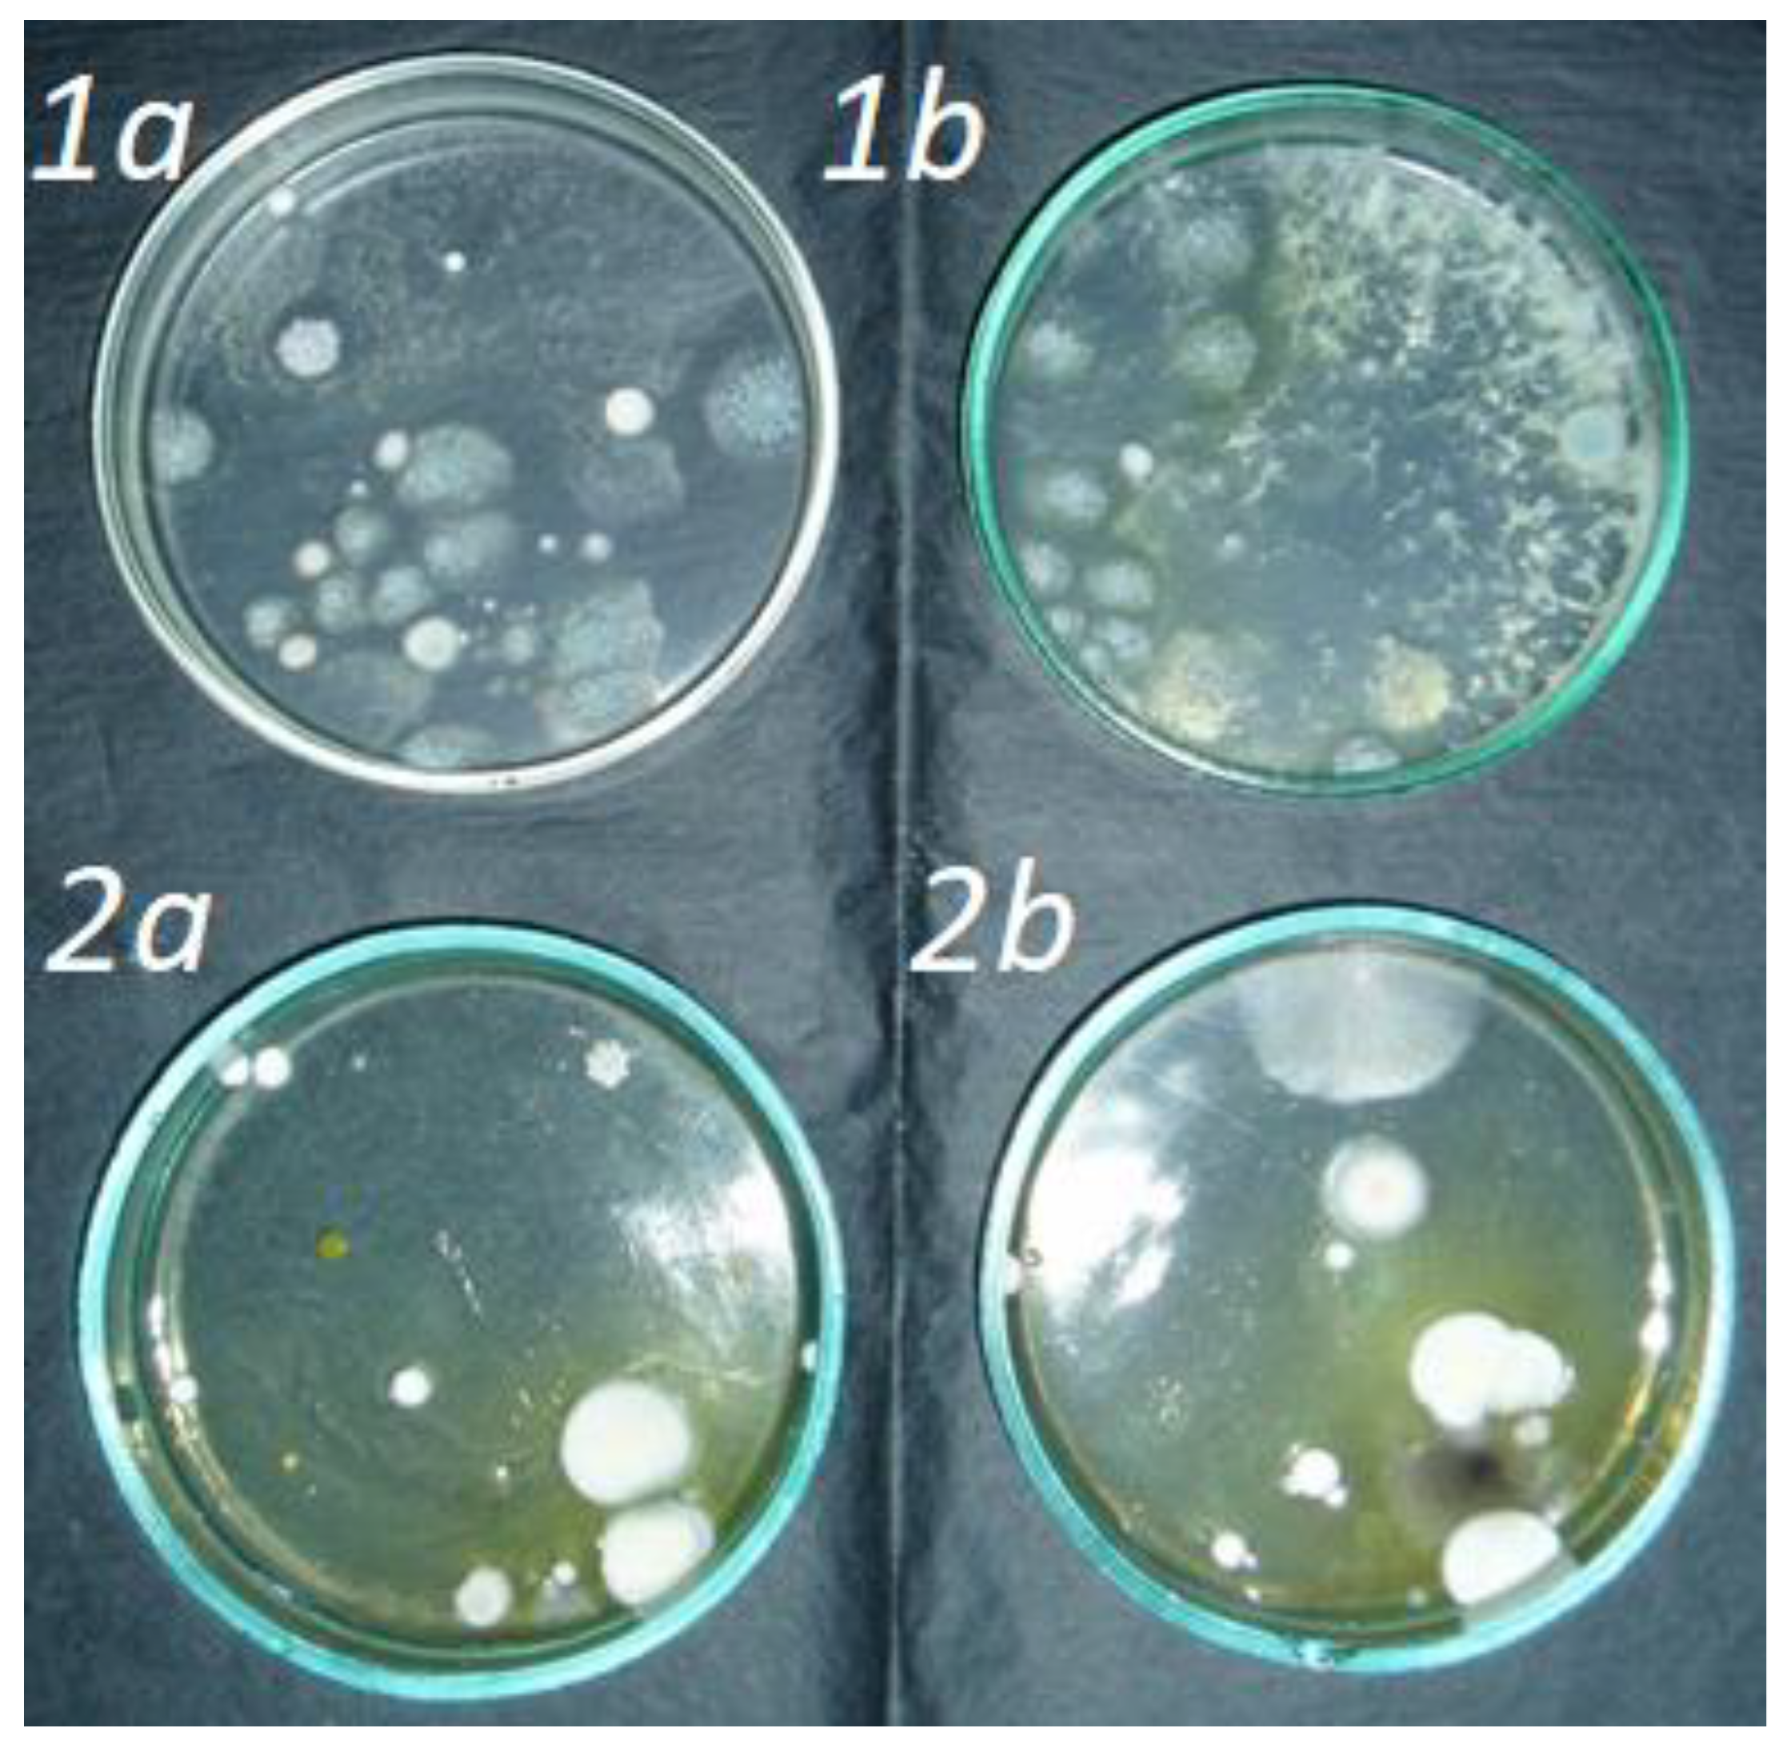
Agronomy 14 01498 g006 Agronomy 14 01498 g006
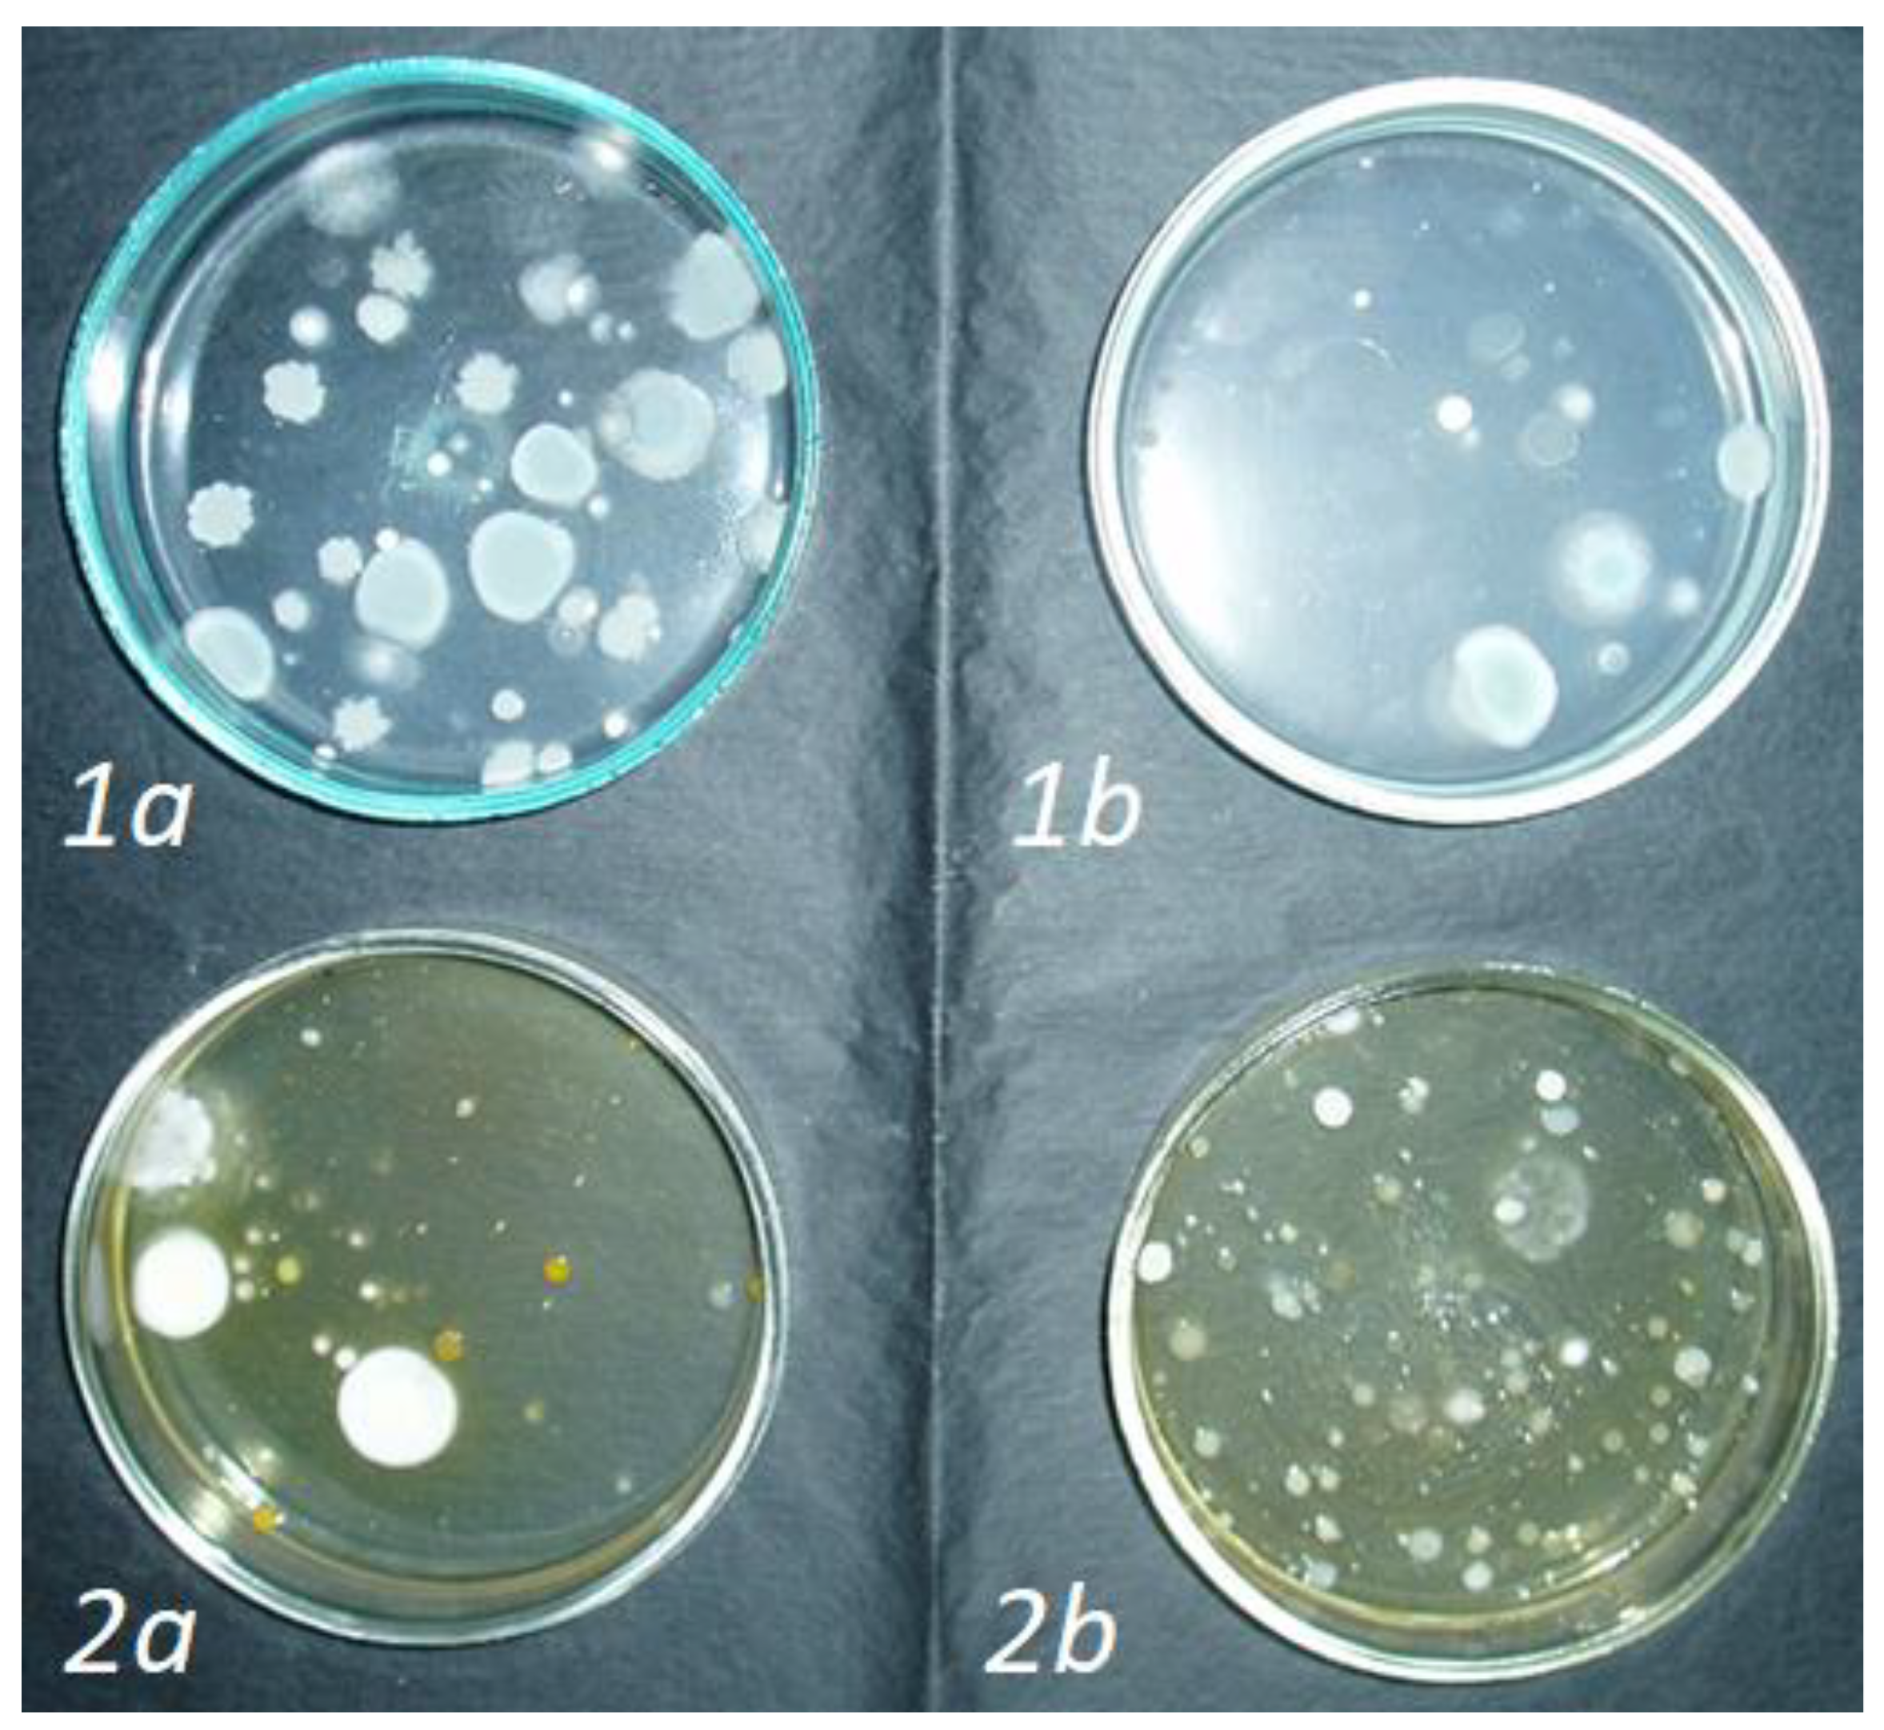
Agronomy 14 01498 g007 Agronomy 14 01498 g007

Prospects for Enhanced Growth and Yield of Blueberry (Vaccinium angustifolium Ait.) Using Organomineral Fertilizers for Reclamation of Disturbed Forest Lands in European Part of Russia
Abstract
1. Introduction
2. Materials and Methods
3. Results
4. Discussion
5. Conclusions
Author Contributions
Funding
Data Availability Statement
Conflicts of Interest
References
- Chibrik, T.S. Basics of Biological Remediation; Ural University Publisher: Ekaterinburg, Russia, 2002; 172p. [Google Scholar]
- Nipa, L.R.; Kovilin, N.V. Reclamation and Landscape Formation; Siberian State Technological University Publisher: Krasnoyarsk, Russia, 2003; 180p. [Google Scholar]
- Lisetsky, F.N.; Goleusov, P.V.; Kukharuk, N.S.; Chepelev, O.A. Ecological aspects of reproduction of the soil—Vegetative cover in the landscapes broken by the mining industry. Res. Russ. 2005, 217, 2233–2250. [Google Scholar]
- Rodin, A.R.; Rodin, S.A.; Vasiliev, S.B.; Silaev, G.V. Forest Reclamation of Landscapes; Moscow State Forest University Publisher: Moscow, Russia, 2014; p. 192. [Google Scholar]
- Polovnikov, A.V. Recultivation and Reclamation of Disturbed Lands; Perm State Agricultural Academy Publisher: Perm, Russia, 2016; p. 51. [Google Scholar]
- Kuczera, L.; Arriens, J.; Bharath, P. The Climate Benefits of Degraded Land Reclamation and Restoration; National Wildlife Federation: Washington, DC, USA, 2022; 16p. [Google Scholar]
- Smetanin, V.I. Recultivation and Development of Disturbed Lands; Kolos: Moscow, Russia, 2000; 96p. [Google Scholar]
- Fesyuk, V.O.; Moroz, I.A.; Chyzhevska, L.T.; Karpiuk, Z.K.; Polianskyi, S.V. Burned Peatlands within the Volyn Region: State, Dynamics, Threats, Ways of Further Use. J. Geol. Geogr. Geoecology 2020, 29, 483–494. [Google Scholar] [CrossRef]
- Tsoraeva, E.N.; Zaitseva, Y.V. Reclamation of Disturbed Land in Russia: State of the Art. IOP Conf. Ser. Earth Environ. Sci. 2022, 988, 022020. [Google Scholar] [CrossRef]
- Inisheva, L.I.; Aristarkhova, V.E.; Porokhina, E.V.; Borovkova, A.F. Depleted Peat Deposits, Its Characterization and Functioning; Tomsk State Pedagogical University Publisher: Tomsk, Russia, 2007; 185p. [Google Scholar]
- Ministry of Natural Resources of the Russian Federation. Main Areas of Action for the Conservation and Rational Use of Peatlands in Russia; Ministry of Natural Resources of the Russian Federation: Moscow, Russia, 2003; 24p. [Google Scholar]
- Podzharov, V.K. Main directions of utilization of depleted peatlands in forestry in Belarus. Probl. For. Silvic. A Collect. Sci. Work. 1998, 49, 8–12. [Google Scholar]
- Skoropanov, S.G. Modern problems of depleted peat deposits. In Rational Use of Peat Soils and Areas of Depleted Peat Deposits in the National Economy; All-Russian Research Institute of Hydraulic Engineering and Land Reclamation Publisher: Moscow, Russia, 1985; pp. 3–5. [Google Scholar]
- Kovalev, N.G.; Pozdnyakov, A.I.; Musekaev, D.A.; Pozdnyakova, L.A. Peat, Peat Soils, Fertilizers; All-Russian Research Institute of Reclaimed Lands Publisher: Moscow, Russia, 1998; 240p. [Google Scholar]
- Tyak, G.V.; Kurlovich, L.E.; Tyak, A.V. Biological reclamation of depleted peatlands through the establishment of forest berry plantations. Bull. Kazan State Agrar. Univ. 2016, 11, 43–46. [Google Scholar] [CrossRef]
- Abdalla, M.; Hastings, A.; Truu, J.; Espenberg, M.; Mander, Ü.; Smith, P. Emissions of methane from northern peatlands: A review of management impacts and implications for future management options. Ecol. Evol. 2016, 6, 7080–7102. [Google Scholar] [CrossRef]
- Sharling, E.A. Influence of economic activity on the state of cranberry stands in the Non-Chernozem Zone of the RSFSR. In Reclamation of Lands in the South-West of the Non-Chernozem Zone of the RSFSR; All-Russian Research Institute of Silviculture and Forestry Mechanization Publisher: Moscow, Russia, 1978; pp. 126–131. [Google Scholar]
- Olenin, A.S. Formation of areas of depleted peat deposits of the country and their practical utilization. In Rational Use of Peat Soils and Areas of Depleted Peat Deposits in the National Economy; All-Russian Research Institute of Reclaimed Lands Publisher: Moscow, Russia, 1985; pp. 3–5. [Google Scholar]
- Sirin, A.A.; Minaeva, T.Y. Peat Bogs of Russia: To Analyze Sectoral Information; Geos: Moscow, Russia, 2001; 90p. [Google Scholar]
- Gronsky, I.Y.; Shnitskovskis, A.E. Some results of long-term research on breeding of bog cranberry on plantations and worked peatlands in Latvia. In Achievements and Prospects in the Field of Inventory, Study of Rational Development and Protection of Non-Timber Forest Resources on the Territory of the European Part of the USSR; Tarty, Estonia, 1986; pp. 49–50. [Google Scholar]
- Khudobokin, T.M. Cultivation of cranberries, cranberries and blueberries on peat excavations. In Ecological and Biological Study of Berry Plants of the Lingonberry Family and the Experience of Developing Their Industrial Culture in the USSR; Gantsevichi, Belarus, 1991; pp. 200–201. [Google Scholar]
- Yakovlev, A.P.; Vogulkin, K.E. Introduction of cultivated varieties of Vaccinium vitis-idaea L. on depleted peatlands of the Belarusian Lakes Region. New Non-Tradit. Plants Prospect. Their Use 2003, 2, 193–195. [Google Scholar]
- Noormets, M.; Karp, K.; Paal, T. Recultivation of Opencast Peat Pits with Vaccinium Culture in Estonia. Ecosyst. Sustain. Dev. 2003, 2, 1005–1014. [Google Scholar]
- Vahejõe, K.; Albert, T.; Noormets, M.; Karp, K.; Paal, T.; Starast, M.; Värnik, R. Berry Cultivation in Cutover Peatlands in Estonia: Agricultural and Economical Aspects. Balt. For. 2010, 16, 264–272. [Google Scholar]
- Bussieres, J.; Rochefort, L.; Lapointe, L. Cloudberry Cultivation in Cutover Peatland: Improved Growth on Less Decomposed Peat. Can. J. Plant Sci. 2015, 95, 479–489. [Google Scholar] [CrossRef]
- Makeev, V.A.; Tyak, G.V.; Makeeva, G.Y. Experience of cultivation of narrow-leaved blueberry on depleted peatlands of the Kostroma region. Forestry Inf. 2017, 2, 91–102. [Google Scholar]
- Soots, K.; Olt, J. Non-stationary processing centre for small and medium-sized blueberry farms. A Review. Res. Agric. Eng. 2017, 63, 136–144. [Google Scholar] [CrossRef]
- Marozau, A.; Gordej, D. Formation of cover, yield and low winter temperature tolerance of lowbush blueberry (Vaccinium angustifolium Ait.) on the cutover raised-bog peatlands of Belarussian Lakeland. Balt. For. 2019, 25, 69–82. [Google Scholar] [CrossRef]
- Butkus, V. Recultivation of Depleted Peatlands by Sowing Cranberries; Institute of Botany: Vilnius, Lithuania, 1987; 4p. [Google Scholar]
- Ripa, A.K. New berry crops on spent peatlands. In Plantation Cultivation of Forest Mushrooms and Berries; Gomel, Belarus, 1998; pp. 37–39. [Google Scholar]
- Sidorovich, E.A.; Ruban, N.N.; Kurlovich, T.V. Plantation cultivation of high bilberry on reclaimed peatlands of Belarusian Polessie. Vesti Sci. Ac. BSSR Agric. Ser. 1987, 4, 66–69. [Google Scholar]
- Budriuniene, D. Regeneration Potentials of Raised Bogs. Biologija 1995, 3–4, 84–85. [Google Scholar]
- Paal, T.; Starast, M.; Noormets-Šanski, M.; Vool, E.; Tasa, T.; Karp, K. Influence of Liming and Fertilization on Lowbush Blueberry in Harvested Peat Field Condition. Sci. Hortic. 2011, 130, 157–163. [Google Scholar] [CrossRef]
- Rupasova, Z.A.; Yakovlev, A.P.; Antohina, S.P.; Vashkevich, M.N.; Yaroshuk, A.A.; Aleshchenkova, Z.M.; Kolomiets, E.I. Peculiarities of the Growth of virgin blueberry plants on the developed peat deposit with the application of mineral and microbial fertilizers. Proc. Natl. Acad. Sci. Belarus Biol. Ser. 2018, 63, 48–59. [Google Scholar] [CrossRef]
- Karlsons, A.; Osvalde, A. Effect of Foliar Fertilization of Microelements on Highbush Blueberry (Vaccinium corymbosum L.) Nutrient Status and Yield Components in Cutover Peatlands. Agron. Res. 2019, 17, 133–143. [Google Scholar]
- Galetta, D.J. Blueberries and cranberries. In Breeding of Fruit Plants; Kolos: Moscow, Russia, 1981; pp. 215–273. [Google Scholar]
- Pavlovsky, N.B. Systematic position and classification of blueberry varieties of the Cyanococcus section. Fruit Growing. 2013, 25, 533–543. [Google Scholar]
- Hildreth, A.C. Propagation of the Lowbush Blueberry. Am. Soc. Hortic. Sci. 1929, 26, 91–92. [Google Scholar]
- Bouchard, A.R. La végétation, les sols et la productivité fruitière de Vaccinium angustifolium et V. myrtilloides dans les bleuetières du Saguenay—Lac-Saint-Jean. Natur. Can. 1986, 113, 125–133. [Google Scholar]
- Eck, P.; Childers, N.F. The Blueberry Industry. In Blueberry Culture; Rutgers Univ. Press: New Brunswick, NJ, USA, 1966; pp. 3–13. [Google Scholar]
- Warman, P.R. The Effects of Pruning, Fertilizers and Organic Amendments on Lowbush Blueberry Production. Plantaled Soil. 1987, 101, 67–72. [Google Scholar] [CrossRef]
- Barker, W.G.; Hall, I.V.; Aalders, L.E.; Wood, G.W. The Lowbush Blueberry Industry in Eastern Canada. Econ. Bot. 1964, 18, 357–365. [Google Scholar] [CrossRef]
- Blatt, C.R. Management Practices and Marketable Yields of Lowbush Blueberries. Hort Sci. 1983, 18, 938–940. [Google Scholar] [CrossRef]
- Hancock, J.F.; Draper, A.D. Blueberry Culture in North America. Hort Sci. 1989, 24, 551–556. [Google Scholar] [CrossRef]
- Hepler, P.R.; Ismail, A.A. The Split Block: A Useful Design for Extension and Research in Lowbush Blueberries. Hort Sci. 1985, 20, 735–737. [Google Scholar] [CrossRef]
- Paré, M.C.; Chagnon, P.-L.; Plourde, J.; Legendre-Guillemin, V. Apatite Stimulates the Deposition of Glomalin-Related Soil Protein in a Lowbush Blueberry Commercial Field. Agriculture 2019, 9, 52. [Google Scholar] [CrossRef]
- Sidorovich, E.A.; Ruban, N.N.; Kurlovich, T.V. Plantation cultivation of high blueberries on recultivated peat bogs of the Belarusian Polesie. News BSSR Acad. Sci. Agric. Sci. Ser. 1987, 4, 66–69. [Google Scholar]
- Rupasova, Z.A.; Reshetnikov, V.N.; Ruban, N.N.; Ignatenko, V.A.; Yakovlev, A.P.; Pyatka, F.S.; Parfeyonov, V.I. Highbush Blueberry: Assessment of Adaptive Potential during Introduction in Belarus; Belaruskaya Navuka: Minsk, Belarus, 2007; 442p. [Google Scholar]
- Yarborough, D.E. Cultivated Lowbush Blueberry (Vaccinium angustifolium) Establishment and Management. J. Jilin Univ. 2009, 31, 556–560. [Google Scholar] [CrossRef]
- Pavlovsky, N.B. Methods of vegetative reproduction of high blueberries (Vaccinium corymbosum L.). Fruit Berry Grow. Russ. 2010, 22, 328–340. [Google Scholar]
- Makarov, S.S.; Vinogradova, V.S.; Tyak, G.V.; Babich, N.A. Theory and Practice of Reproduction and Plantation Cultivation of Forest Berry Plants Rubus arcticus L., Oxycoccus palustris Pers. and Vaccinium angustifolium Ait; Kostroma State Agricultural Academy Publisher: Karavaevo, Russia, 2021; 394p. [Google Scholar]
- Makarov, S.S.; Upadyshev, M.T.; Khamitov, R.S.; Antonov, A.M.; Kulikova, E.I.; Kuznetsova, I.B. Prospects of Industrial Cultivation and Biotechnological Methods of Reproduction of Forest Berry Plants; Kolos-S: Moscow, Russia, 2023; 152p. [Google Scholar]
- Bailey, J.S.; Smith, C.T.; Weatherby, R.T. The Nutritional Status of the Cultivated Blueberry as Revealed by Leaf Analysis. Proc. Am. Soc. Hortic. Sci. 1949, 54, 205–208. [Google Scholar]
- Baranova, I.I.; Smirnova, L.M.; Ershova, G.F. The content of chemicals in blueberries and blueberries of various habitats. In Resources of Berry and Medicinal Plants and Methods of Its Study; Karelian Branch of the USSR Academy of Sciences Publisher: Petrozavodsk, Russia, 1975; pp. 79–81. [Google Scholar]
- Cummings, G.A. Plant and Soil Effects of Fertilizer and Lime Applied to Highbush Blueberries. J. Amer. Soc. Hort. Sci. 1978, 103, 302–305. [Google Scholar] [CrossRef]
- Gorbunov, A.B.; Dneprovsky, Y.M.; Snakina, T.I. Features of growth and productivity of blueberries in the conditions of culture. In New Food Plants; Nauka: Novosibirsk, Russia, 1978; pp. 61–77. [Google Scholar]
- Balandina, T.P. Common blueberry: Momenclature, intraspecific systematics and geographical distribution. Biol. Flora Mosc. Reg. 1983, 7, 177–187. [Google Scholar]
- Arnold, J.T.; Thompson, L.F. Chlorosis in Blueberries: A Soil-plant Investigation. J. Plant Nutr. 2008, 5, 747–753. [Google Scholar] [CrossRef]
- Chulkina, V.S. Epiphytotiological Classification of Infectious Plant Diseases and Its Practical Use in the Development of Protective Measures Systems; Siberian branch of the All-Union Academy of Agricultural Sciences named after Lenin Publisher: Novosibirsk, Russia, 1988; 56p. [Google Scholar]
- Vorobyova, I.G.; Pishchalnikova, E.F.; Gorbunov, A.B.; Snakina, T.I. Species composition of micromycetes on introduced plants of the Vaccinaceae family in the Central Siberian Botanical Garden of the Siberian Branch of the Russian Academy of Sciences. Sib. Ecol. J. 1999, 3, 329–332. [Google Scholar]
- Vinogradova, V.S.; Smirnova, Y.V. Physiology and Biochemistry of Plants: Laboratory Workshop; KSAA Publisher: Karavaevo, Russia, 2014; 98p. [Google Scholar]
- Doughty, C.C.; Adams, E.B.; Martin, L.W. Highbush Blueberry Production in Washington and Oregon; Washington State University: Washington, DC, USA, 1981; 25p. [Google Scholar]
- Ballinger, W.E.; Kushman, L.J.; Brooks, J.F. Influence of Crop Load and Nitrogen Applications upon Yield and Fruit Qualities of ’Wolcott’ Blueberries. Proc. Am. Soc. Hortic. Sci. 1963, 42, 264–276. [Google Scholar]
- Gladkova, L.I. Cultivation of Blueberries and Cranberries; Research Institute for Technical and Economic Research of Agriculture Publisher: Moscow, Russia, 1974; 63p. [Google Scholar]
- Eck, P. Optimum Potassium Nutritional Level for Production of Highbush Blueberry. J. Amer. Soc. Hort. Sci. 1983, 108, 520–522. [Google Scholar]
- Makarov, S.S.; Kuznetsova, I.B.; Chudetsky, A.I.; Rodin, S.A. Obtaining High-Quality Planting Material of Forest Berry Plants by Clonal Micropropagation for Restoration of Cutover Peatlands. Russ. For. J. 2021, 2, 21–29. [Google Scholar] [CrossRef]
- Makarov, S.S.; Rodin, S.A.; Kuznetsova, I.B.; Chudetsky, A.I.; Tsaregradskaya, S.Y. The influence of lighting on rhizogenesis of berry plants during clonal micropropagation. Food Process. Tech. Technol. 2021, 51, 520–528. [Google Scholar] [CrossRef]
- Makarov, S.S.; Upadyshev, M.T.; Kuznetsova, I.B.; Zaushintsena, A.V.; Kulikova, E.I.; Surina, E.A. Application of lighting of different spectral ranges in clonal micropropagation of forest berry plants. Russ. For. J. 2022, 6, 82–93. [Google Scholar] [CrossRef]
- Makarov, S.S.; Kuznetsova, I.B.; Zaushintsena, A.V.; Kulikova, E.I.; Tyak, G.V.; Kurlovich, T.V. Increasing the efficiency of multi-purpose forest management on exhausted peatlands. Russ. For. J. 2022, 3, 91–102. [Google Scholar] [CrossRef]
- Ermakov, A.I. (Ed.) Methods of Biochemical Research of Plants; Agropromizdat: Leningrad, Russia, 1987; p. 430. [Google Scholar]
- Dospekhov, B.A. Methodology of Field Experience (With the Basics of Statistical Processing of Research Results); Alliance: Moscow, Russia, 2011; 350p. [Google Scholar]
- Tretyakov, N.N.; Karnaukhova, T.V.; Panichkin, L.A. Workshop on Plant Physiology; Agropromizdat: Moscow, Russia, 1990; 271p. [Google Scholar]
- Szegi, J. Soil Microbiological Test Methods; Mezőgazdasági Kiadó: Budapest, Hungary, 1979; 310p. [Google Scholar]
- Bañados, M.P.; Strick, B.C.; Bryla, D.R.; Righetti, T.L. Response of High Bush Blueberry to Nitrogen Fertilizer during Field Establishment. I. Accumulation and Allocation of Fertilizer Nitrogen and Biomass. HortScience 2012, 47, 648–655. [Google Scholar] [CrossRef]
- Bryla, D.R.; Machado, R.M.A. Comparative Effects of Nitrogen Fertigation and Granular Fertilizer Application on Growth and Availability of Soil Nitrogen during Establishment of Highbush Blueberry. Front. Plant Sci. 2011, 2, 1–8. [Google Scholar] [CrossRef]
- Clark, M.J.; Zheng, Y. Fertilization Methods for Organic and Conventional Potted Blueberry Plants. HortScience Horts. 2020, 55, 304–309. [Google Scholar] [CrossRef]
- Hanson, E.J. Nitrogen Fertilization of Highbush Blueberry. Acta Hortic. 2006, 715, 347–351. [Google Scholar] [CrossRef]
- Kozinski, M. Influence of Mulching and Nitrogen Fertilization Rate on Growth and Yield of Highbush Blueberry. Acta Hortic. 2006, 715, 231–235. [Google Scholar] [CrossRef]
- Larco, H.; Strik, B.C.; Bryla, D.R.; Sullivan, D.M. Mulch and Fertilizer Management Practices for Organic Production of Highbush Blueberry. I. Plant Growth and Allocation of Biomass during Establishment. HortScience 2013, 48, 1250–1261. [Google Scholar] [CrossRef]
- Lillerand, T.; Virro, I.; Maksarov, V.V.; Olt, J. Granulometric Parameters of Solid Blueberry Fertilizers and Their Suitability for Precision Fertilization. Agronomy 2021, 11, 1576. [Google Scholar] [CrossRef]
- Medvecký, M.; Daniel, J.; Vollmannova, A.; Zupka, S.; Kopernicka, M. The Content of Polyphenols in Fruit of Highbush Blueberry (Vaccinium corymbosum L.) Relating to Different Fertilizer Application. Food Sci. Food Sci. 2015, 4, 109–113. [Google Scholar] [CrossRef][Green Version]
- Messigaa, A.J.; Haaka, D.; Dorais, M. Blueberry Yield and Soil Properties Response to Long-term Fertigation and Broadcast Nitrogen. Sci. Hortic. 2018, 230, 92–101. [Google Scholar] [CrossRef]
- Muñoz-Vega, P.; Paillán, H.; Serri, H.; Donnay, D.; Sanhueza, C.; Merino, E.; Hirzel, J. Effects of Organic Fertilizers on the Vegetative, Nutritional, and Productive Parameters of Blueberries ‘Corona’, ‘Legacy’, and ‘Liberty’. Chilean J. Agric. Res. 2016, 76, 201–212. [Google Scholar] [CrossRef]
- Nunes de Lima, F.; Yamanishi, O.K.; de Carvalho Pires, M.; Saba, E.D.; Pereira, A.R.; Miranda, G.S. Ecophysiology of the Southern Highbush Blueberry cv. Biloxi in Response to Nitrogen Fertigation. Comun. Sci. 2020, 11, e3245. [Google Scholar] [CrossRef]
- Tasnim, R.; Calderwood, L.; Tooley, B.; Wang, L.; Zhang, Y.-J. Are Foliar Fertilizers Beneficial to Growth and Yield of Wild Lowbush Blueberries? Agronomy 2022, 12, 470. [Google Scholar] [CrossRef]
- Vargas, O.L.; Bryla, D.R. Growth and Fruit Production of Highbush Blueberry Fertilized with Ammonium Sulfate and Urea Applied by Fertigation or as Granular Fertilizer. HortScience 2015, 50, 479–485. [Google Scholar] [CrossRef]
- Wang, X.; Jiao, B.; Yin, Z.; Liu, J. Optimization of Chemical Fertilizer Application for Blueberry Vegetative Growth, Fruit Quality and Soil Condition. Emir. J. Food Agric. 2022, 34, 991–996. [Google Scholar] [CrossRef]
- Williamson, J.G.; Miller, E.P. Effects of Fertilizer Rate and Form on Vegetative Growth and Yield of Southern Highbush Blueberry in Pine Bark Culture. HortTechnology 2009, 19, 152–157. [Google Scholar] [CrossRef]
- Wu, S.Z.; Bai, W.F.; Li, J.H.; Yu, L.; Bai, X.J.; Nie, D.L. Effects of Soil Testing and Formulated Fertilization on Blueberry Variety ‘Brightwell’. J. Cent. South Univ. For. Technol. 2019, 39, 10–18. (In Chinese) [Google Scholar] [CrossRef]
- Zhang, X.; Li, S.; An, X.; Song, Z.; Zhu, Y.; Tan, Y.; Guo, X.; Wang, D. Effects of Nitrogen, Phosphorus and Potassium Formula Fertilization on the Yield and Berry Quality of Blueberry. PLoS ONE 2023, 18, e0283137. (In Chinese) [Google Scholar] [CrossRef]
- Eaton, L.J.; Stratton, G.W.; Sanderson, K.R. Fertilizer Phosphorus in Lowbush Blueberries: Effects and Fate. Acta Hortic. 1997, 446, 447–486. [Google Scholar] [CrossRef]
- Marty, C.; Levesque, J.-A.; Bradley, R.L.; Lafond, J.; Pare, M.C. Lowbush Blueberry Fruit Yield and Growth Response to Inorganic and Organic N-fertilization when Competing with Two Common Weed Species. PLoS ONE 2019, 14, e0226619. [Google Scholar] [CrossRef]
- Ngoc, N.P.; Dang, L.V.; Quynh, L.N.; Hung, N.N. Enhancing Soil Fertility and Lowbush Blueberry (Vaccinium angustifolium) Growth Using Bio-organic Fertilizer. IOP Conf. Ser. Earth Environ. Sci. 2022, 1087, 012077. [Google Scholar] [CrossRef]
- Penney, B.G.; McRae, K.B. Herbicidal weed control and crop-year NPK fertilization improves lowbush blueberry (Vaccinium angustifolium Ait.) production. Can. J. Plant Sci. 2000, 80, 351–361. [Google Scholar] [CrossRef]
- Sanderson, K.; Eaton, L.; Melanson, M.; Wyand, S.; Fillmore, S.; Jordan, C. Maritime Provinces Wild Blueberry Fertilizer Study. Int. J. Fruit Sci. 2008, 8, 52–62. [Google Scholar] [CrossRef]
- Yarborough, D.E.; Hancher, J.J.; Skinner, S.P.; Ismail, A.A. Weed Response, Yield and Economics of Hexazinone and Nitrogen Use in Lowbush Blueberry Production. Weed Sci. 1986, 34, 723–729. [Google Scholar] [CrossRef]
- Guo, X.; Zhao, D.; Hu, J.; Wang, D.; Wang, J.; Shakeel, M. The Effects of Water and Fertilizer Coupling on Plant and Soil Nitrogen Characteristics and Fruit Growth of Rabbiteye Blueberry Plants in a Semi-Arid Region in China. Phyton 2023, 92, 209–223. [Google Scholar] [CrossRef]

| Fertilizer Name | Manufacturer | Composition | Dose, g/kg | ||||||||||
|---|---|---|---|---|---|---|---|---|---|---|---|---|---|
| Ratio of Mobile Forms | Contents of Elements, % | Additional Components | |||||||||||
| N | P | K | Zn | Fe | Cu | S | Mn | Mo | B | ||||
| Mineral fertilizer NPK 16:16:16 | Minudobreniya, Russia | 16 | 16 | 16 | 6.0 | ||||||||
| Complex mineral fertilizer “Solution for Ericaceae” (Ericaceae fertilizers) | Buyskiy Himicheskiy Zavod, Russia | 20 | 16 | 10 | 0.01 | 0.01 | 5.6 | 0.1 | 0.001 | 0.01 | 4.0 | ||
| New organomineral fertilizer (New OMF) | Author’s development | 8 | 8 | 8 | 0.2 | 0.5 | 0.4 | Vermicompost containing spore forms of bacteria Bacillus subtillis Ch- 13 and B. mucilaginosus, and Azotobakter chroococcum | 6.4 | ||||
| Variation | The Number of Soil Groups of Microorganisms, Thousand CFU/g | |||
|---|---|---|---|---|
| Ammonifiers | Micromycetes | Phosphate-Mobilizing | Nitrogen-Fixing | |
| Control (peat) | 20 | 180 | 20 | 20 |
| Peat + Ericaceae fertilizers 6 g/kg | 50 | 360 | 30 | 20 |
| Peat + NPK 16:16:16 4 g/kg | 40 | 370 | 20 | 10 |
| Peat + New OMF 6.4 g/kg | 160 | 210 | 60 | 30 |
| Variation | pH | Phosphorus, mg/kg | Potassium, mg/kg | Nitrogen Total mg/kg |
|---|---|---|---|---|
| Control (peat) | 2.7 | 16.5 | 51.2 | <2.5 |
| Peat + Ericaceae fertilizers 6 g/kg | 3.2 | 21.8 | 52.0 | 8.6 |
| Peat + NPK 16:16:16 4 g/kg | 2.8 | 21.5 | 68.9 | 12.1 |
| Peat + New OMF 6.4 g/kg | 3.8 | 26.1 | 90.4 | 25.8 |
| LSD05 | 0.388 | 0.521 | 0.189 |
| r | Ammonifiers | Micromycetes | Phosphate- Mobilizing | Nitrogen- Fixing | pH | Phosphorus, mg/kg | Potassium, mg/kg | Nitrogen Total mg/kg |
|---|---|---|---|---|---|---|---|---|
| Ammonifiers | 1 | |||||||
| Micromycetes | 0.006941989 | 1 | ||||||
| Phosphate-mobilizing | 0.022942276 | 0.076739 | 1 | |||||
| Nitrogen-fixing | 0.299711926 | 0.287705 | 0.098321 | 1 | ||||
| pH | 0.11277192 | 0.40678 | 0.761005 | 0.031005 | 1 | |||
| Phosphorus, mg/kg | 0.582131913 | 0.03001 | 0.268559 | 0.540517 | 0.057723 | 1 | ||
| Potassium, mg/kg | 0.858506841 | 0.039469 | 0.000392 | 0.674965 | 0.106931 | 0.703417 | 1 | |
| Nitrogen total, mg/kg | 0.732324451 | 0.009067 | 0.08089 | 0.738821 | 0.005461 | 0.895738 | 0.929041 | 1 |
| Variation | Photosynthesis Productivity, mgS/dm2 | Leaf Area of the Plant, dm2 | The Total Surface of the Roots, m−3 | Working Surface of Roots, m−3 | Root Weight, g |
|---|---|---|---|---|---|
| June | |||||
| Control (peat) | 2.58 | 2.2 | 23.8 | 15.9 | 1.5 |
| Peat + Ericaceae fertilizers 6 g/kg | 2.43 | 2.3 | 33.1 | 22.6 | 1.7 |
| Peat + NPK 16:16:16 4 g/kg | 2.69 | 2.2 | 32.4 | 21.6 | 1.6 |
| Peat + New OMF 6.4 g/kg | 2.76 | 2.4 | 33.4 | 22.9 | 1.7 |
| LSD05 | 0.067 | 0.441 | 0.923 | 0.641 | 0.216 |
| July | |||||
| Control (peat) | 2.44 | 3.1 | 46.3 | 23.2 | 2.8 |
| Peat + Ericaceae fertilizers 6 g/kg | 2.52 | 3.5 | 53.1 | 27.3 | 3.3 |
| Peat + NPK 16:16:16 4 g/kg | 2.89 | 3.8 | 55.9 | 28.5 | 3.2 |
| Peat + New OMF 6.4 g/kg | 3.81 | 3.7 | 58.1 | 29.1 | 3.3 |
| LSD05 | 0.397 | 0.565 | 0.416 | 0.493 | 0.49 |
| September | |||||
| Control (peat) | 3.86 | 6.8 | 31.8 | 25.9 | 3.8 |
| Peat + Ericaceae fertilizers 6 g/kg | 4.56 | 8.1 | 44.8 | 32.6 | 4.3 |
| Peat + NPK 16:16:16 4 g/kg | 4.61 | 8.4 | 42.0 | 31.4 | 4.2 |
| Peat + New OMF 6.4 g/kg | 4.82 | 8.5 | 54.3 | 33.3 | 4.7 |
| LSD05 | 0.301 | 0.795 | 0.998 | 1.588 | 0.478 |
| r | Photosynthesis Productivity, mgS/dm2 | Leaf Area of the Plant, dm2 | The Total Surface of the Roots, m−3 | Working Surface of Roots, m−3 | Root Weight, g |
|---|---|---|---|---|---|
| Photosynthesis productivity, mgS/dm2 | 1 | ||||
| Leaf area of the plant, dm2 | 0.742655 | 1 | |||
| The total surface of the roots, m−3 | 0.22798 | 0.005361 | 1 | ||
| Working surface of roots, m−3 | 0.79425 | 0.894512 | 0.03691 | 1 | |
| Root weight, g | 0.747372 | 0.893164 | 0.023431 | 0.996802 | 1 |
| Variation | Yield, g/Bush | Sugar, % | Sugar Collection, g/Plant | Total Acidity, % | Dry Matter, % | Collection of Dry Matter g/Plant | Vitamin C, mg/% |
|---|---|---|---|---|---|---|---|
| Control (peat) | 150.1 | 10.2 | 15.3 | 0.60 | 9.8 | 14.7 | 9.4 |
| Peat + Ericaceae fertilizers 6 g/kg | 163.5 | 11.0 | 17.98 | 0.57 | 10.3 | 17.38 | 10.6 |
| Peat + NPK 16:16:16 4 g/kg | 160.2 | 11.1 | 17.76 | 0.71 | 10.1 | 16.16 | 10.2 |
| Peat + New OMF 6.4 g/kg | 190.2 | 11.9 | 22.61 | 0.60 | 10.8 | 20.52 | 10.4 |
| LSD05 | 9.603 | 0.386 | 0.446 |
| Elements, mg/kg | Variation | |||
|---|---|---|---|---|
| Control (Peat) | Peat + Ericaceae Fertilizers 6 g/kg | Peat + NPK 16:16:16 4 g/kg | Peat + New OMF 6.4 g/kg | |
| In the substrate | ||||
| B | 1.39 ± 0.12 | 2.10 ± 0.16 | 1.18 ± 0.09 | 2.32 ± 0.19 |
| Ca | 2813 ± 89.55 | 3102 ± 122.42 | 1120 ± 94.22 | 3562 ± 147.32 |
| Cu | 0.48 ± 0.05 | 1.12 ± 0.10 | 0.99 ± 0.07 | 0.38 ± 0.04 |
| Fe | 32.8 ± 2.65 | 39.16 ± 3.02 | 28.3 ± 2.12 | 59.8 ± 5.14 |
| I | 1.26 ± 0.11 | 2.20 ± 0.17 | 1.01 ± 0.08 | 0.90 ± 0.06 |
| K | 696 ± 55.87 | 423 ± 35.78 | 218 ± 17.44 | 836 ± 69.21 |
| Mg | 753 ± 68.20 | 628 ± 55.78 | 307 ± 19.98 | 523 ± 36.53 |
| Mn | 70 ± 6.54 | 189 ± 15.56 | 101 ± 9.45 | 308 ± 20.45 |
| P | 214 ± 11.49 | 320 ± 28.96 | 173 ± 11.20 | 389 ± 29.21 |
| In plants | ||||
| B | 59.6 ± 4.95 | 78.9 ± 6.88 | 78.0 ± 6.65 | 89.3 ± 7.54 |
| Ca | 4123 ± 130.77 | 6215 ± 250.32 | 5787 ± 211.38 | 7336 ± 299.33 |
| Cu | 5.32 ± 0.39 | 6.77 ± 0.48 | 6.33 ± 0.45 | 8.12 ± 0.75 |
| Fe | 33.6 ± 2.86 | 49.6 ± 4.02 | 42.3 ± 3.55 | 48.2 ± 3.87 |
| I | 1.12 ± 0.09 | 1.99 ± 0.15 | 2.13 ± 0.19 | 2.03 ± 0.14 |
| K | 15,215 ± 677.90 | 17,339 ± 732.56 | 16,315 ± 690.46 | 18,102 ± 760.25 |
| Mg | 2153 ± 78.99 | 4012 ± 167.65 | 3521 ± 144.32 | 4592 ± 178.88 |
| Mn | 1520 ± 92.24 | 1927 ± 97.05 | 1899 ± 89.79 | 2184 ± 104.67 |
| P | 1998 ± 90.21 | 2834 ± 108.45 | 2484 ± 102.23 | 3511 ± 125.87 |
| In fruits | ||||
| B | 0.25 ± 0.02 | 0.24 ± 0.02 | 0.23 ± 0.03 | 0.15 ± 0.01 |
| Ca | 18.44 ± 0.98 | 19.12 ± 1.15 | 16.1 ± 0.95 | 23.12 ± 1.86 |
| Cu | 2.32 ± 0.18 | 2.30 ± 0.19 | 2.18 ± 0.17 | 2.10 ± 0.15 |
| Fe | 180.6 ± 12.13 | 189.5 ± 13.66 | 170.2 ± 11.14 | 200.1 ± 16.65 |
| I | 1.50 ± 0.10 | 1.13 ± 0.08 | 1.10 ± 0.08 | 0.96 ± 0.06 |
| K | 64.2 ± 5.04 | 77.30 ± 6.27 | 51.11 ± 4.56 | 82.31 ± 6.97 |
| Mg | 9.66 ± 0.73 | 10.87 ± 0.81 | 8.96 ± 0.67 | 11.30 ± 0.92 |
| Mn | 95.70 ± 8.01 | 106.31 ± 9.88 | 90.30 ± 7.88 | 118.32 ± 10.22 |
| P | 7.25 ± 0.55 | 11.98 ± 0.90 | 13.2 ± 1.18 | 14.12 ± 1.21 |
Disclaimer/Publisher’s Note: The statements, opinions and data contained in all publications are solely those of the individual author(s) and contributor(s) and not of MDPI and/or the editor(s). MDPI and/or the editor(s) disclaim responsibility for any injury to people or property resulting from any ideas, methods, instructions or products referred to in the content. |
© 2024 by the authors. Licensee MDPI, Basel, Switzerland. This article is an open access article distributed under the terms and conditions of the Creative Commons Attribution (CC BY) license (https://creativecommons.org/licenses/by/4.0/).
Share and Cite
Makarov, S.S.; Vinogradova, V.S.; Khanbabaeva, O.E.; Makarova, T.A.; Chudetsky, A.I.; Sokolkina, A.I. Prospects for Enhanced Growth and Yield of Blueberry (Vaccinium angustifolium Ait.) Using Organomineral Fertilizers for Reclamation of Disturbed Forest Lands in European Part of Russia. Agronomy 2024, 14, 1498. https://doi.org/10.3390/agronomy14071498
Makarov SS, Vinogradova VS, Khanbabaeva OE, Makarova TA, Chudetsky AI, Sokolkina AI. Prospects for Enhanced Growth and Yield of Blueberry (Vaccinium angustifolium Ait.) Using Organomineral Fertilizers for Reclamation of Disturbed Forest Lands in European Part of Russia. Agronomy. 2024; 14(7):1498. https://doi.org/10.3390/agronomy14071498
Chicago/Turabian StyleMakarov, Sergey S., Vera S. Vinogradova, Olga E. Khanbabaeva, Tatyana A. Makarova, Anton I. Chudetsky, and Anastasia I. Sokolkina. 2024. "Prospects for Enhanced Growth and Yield of Blueberry (Vaccinium angustifolium Ait.) Using Organomineral Fertilizers for Reclamation of Disturbed Forest Lands in European Part of Russia" Agronomy 14, no. 7: 1498. https://doi.org/10.3390/agronomy14071498
APA StyleMakarov, S. S., Vinogradova, V. S., Khanbabaeva, O. E., Makarova, T. A., Chudetsky, A. I., & Sokolkina, A. I. (2024). Prospects for Enhanced Growth and Yield of Blueberry (Vaccinium angustifolium Ait.) Using Organomineral Fertilizers for Reclamation of Disturbed Forest Lands in European Part of Russia. Agronomy, 14(7), 1498. https://doi.org/10.3390/agronomy14071498

